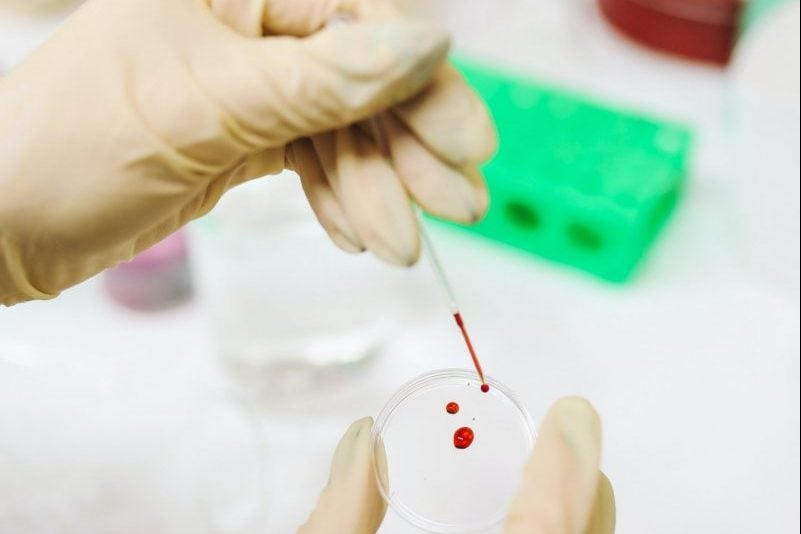

Report: HIV infections drop in Morocco, soar across MENA region
Morocco has seen a 35 percent decline in new HIV infections between 2010 and 2023, according to a recent report by Frontline AIDS . This decrease stands in sharp contrast to trends across the Middle East and North Africa (MENA), where the overall number of new infections has risen significantly.
The report attributes Morocco’s progress to a strong national commitment to HIV prevention, including the development of a comprehensive new strategy to combat sexually transmitted infections, despite challenges in healthcare access in rural areas.
While Morocco has managed to reduce new infections, the report paints a much grimmer picture for the broader region. Egypt recorded an increase of more than 600 percent in new HIV cases over the same period, while Lebanon and Tunisia saw respective increases of 79 and 59 percent.
Across the MENA region as a whole, new infections rose by 116 percent, with more than 22,000 cases registered between 2010 and 2023. This figure accounts for roughly 1.77 percent of the global total of new HIV infections.
Despite the upward trend in infections, AIDS-related deaths in the region decreased by 6 percent, aligning with a global decline in both new infections and deaths—down 39 percent and 51 percent respectively.
However, the MENA region is increasingly seen as an outlier, with the report warning that the lack of political will and inadequate funding is undermining efforts to curb the spread of the virus.
The report further stresses that stigma and discrimination, particularly against LGBTQ+ individuals, sex workers, and drug users, continue to restrict access to crucial services, exacerbating the crisis.
In Morocco, despite the decline in new infections, marginalized groups remain particularly vulnerable. The report notes that social stigma toward the LGBTQ+ community still impedes access to testing and treatment services.
Nonetheless, Morocco’s preventive strategies are considered among the more robust in the region, showing that political commitment and structured health responses can produce tangible results, even in resource-constrained settings.
The report urges governments in the region to act decisively to reverse the current trend, emphasizing the need for long-term national investment rather than dependence on international donors.
It calls for updated strategic plans, expanded access to testing and treatment, greater transparency in healthcare budgets, and inclusive policymaking that incorporates civil society and community voices. In addition, the report highlights the importance of integrating preventative measures such as pre-exposure prophylaxis (PrEP), condom promotion, and sexual education into national health systems.
Speaking to Moroccan media, Mohamed El Khomass, head of international programs at the Moroccan AIDS Prevention Association, expressed concern that the actual number of infections may be significantly higher than official figures suggest. He linked the increase in regional infections to limited testing and a lack of precise data on vulnerable groups, which, in his view, undermines efforts to fully address the epidemic. The Frontline AIDS report concludes by urging the United Nations to step up support for grassroots organizations and ensure that national governments remain accountable to international HIV eradication goals.
The post Report: HIV infections drop in Morocco, soar across MENA region appeared first on English - Morocco News .
Comments
Post a Comment